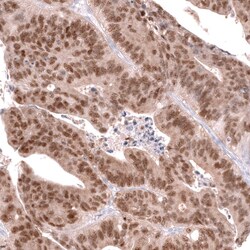
CDX2 Antibody (CL12967) - Azide and BSA Free, Novus Biologicals 100 ul;

missing translation for 'onlineSavingsMsg'
Learn More
Learn More
CDX2 Antibody (CL12967) - Azide and BSA Free, Novus Biologicals™
Mouse Monoclonal Antibody
Brand: Novus Biologicals NBP3-44392
This item is not returnable.
View return policy
Description
CDX2 Monoclonal antibody specifically detects CDX2 in Human samples. It is validated for Western Blot,Immunohistochemistry (Paraffin),Immunocytochemistry/ Immunofluorescence,Immunohistochemistry
Specifications
| CDX2 | |
| Monoclonal | |
| LYOPH | |
| Western Blot 1 μg/mL, Immunocytochemistry/ Immunofluorescence 2-10 μg/mL, Immunohistochemistry-Paraffin 1:50 - 1:200 | |
| caudal type homeo box transcription factor 2, caudal type homeobox 2, Caudal-type homeobox protein 2, CDX-3, CDX3caudal type homeobox transcription factor 2, homeobox protein CDX-2 | |
| This antibody was generated using a synthetic peptide of Q99626, with the exact immunogen sequence remaining proprietary. | |
| 100 μL | |
| Cancer, Chromatin Research, DNA Repair, Growth and Development, Transcription Factors and Regulators | |
| 1045 | |
| Human | |
| Purified |
| Western Blot, Immunohistochemistry (Paraffin), Immunocytochemistry/Immunofluorescence, Immunohistochemistry | |
| CL12967 | |
| Unconjugated | |
| Lyophilized in 5% Trehalose. | |
| Mouse | |
| Protein A purified | |
| RUO | |
| Primary | |
| Centrifuge the vial of lyophilized antibody at 12,000 x g for 20 seconds. Reconstitute by adding sterile, distilled water to achieve a final antibody concentration of 1mg/mL. | |
| Store at 4⪚C short term. Aliquot and store at -20⪚C long term. Avoid freeze-thaw cycles. | |
| IgG1 |
Product Content Correction
Your input is important to us. Please complete this form to provide feedback related to the content on this product.
Product Title
Spot an opportunity for improvement?Share a Content Correction